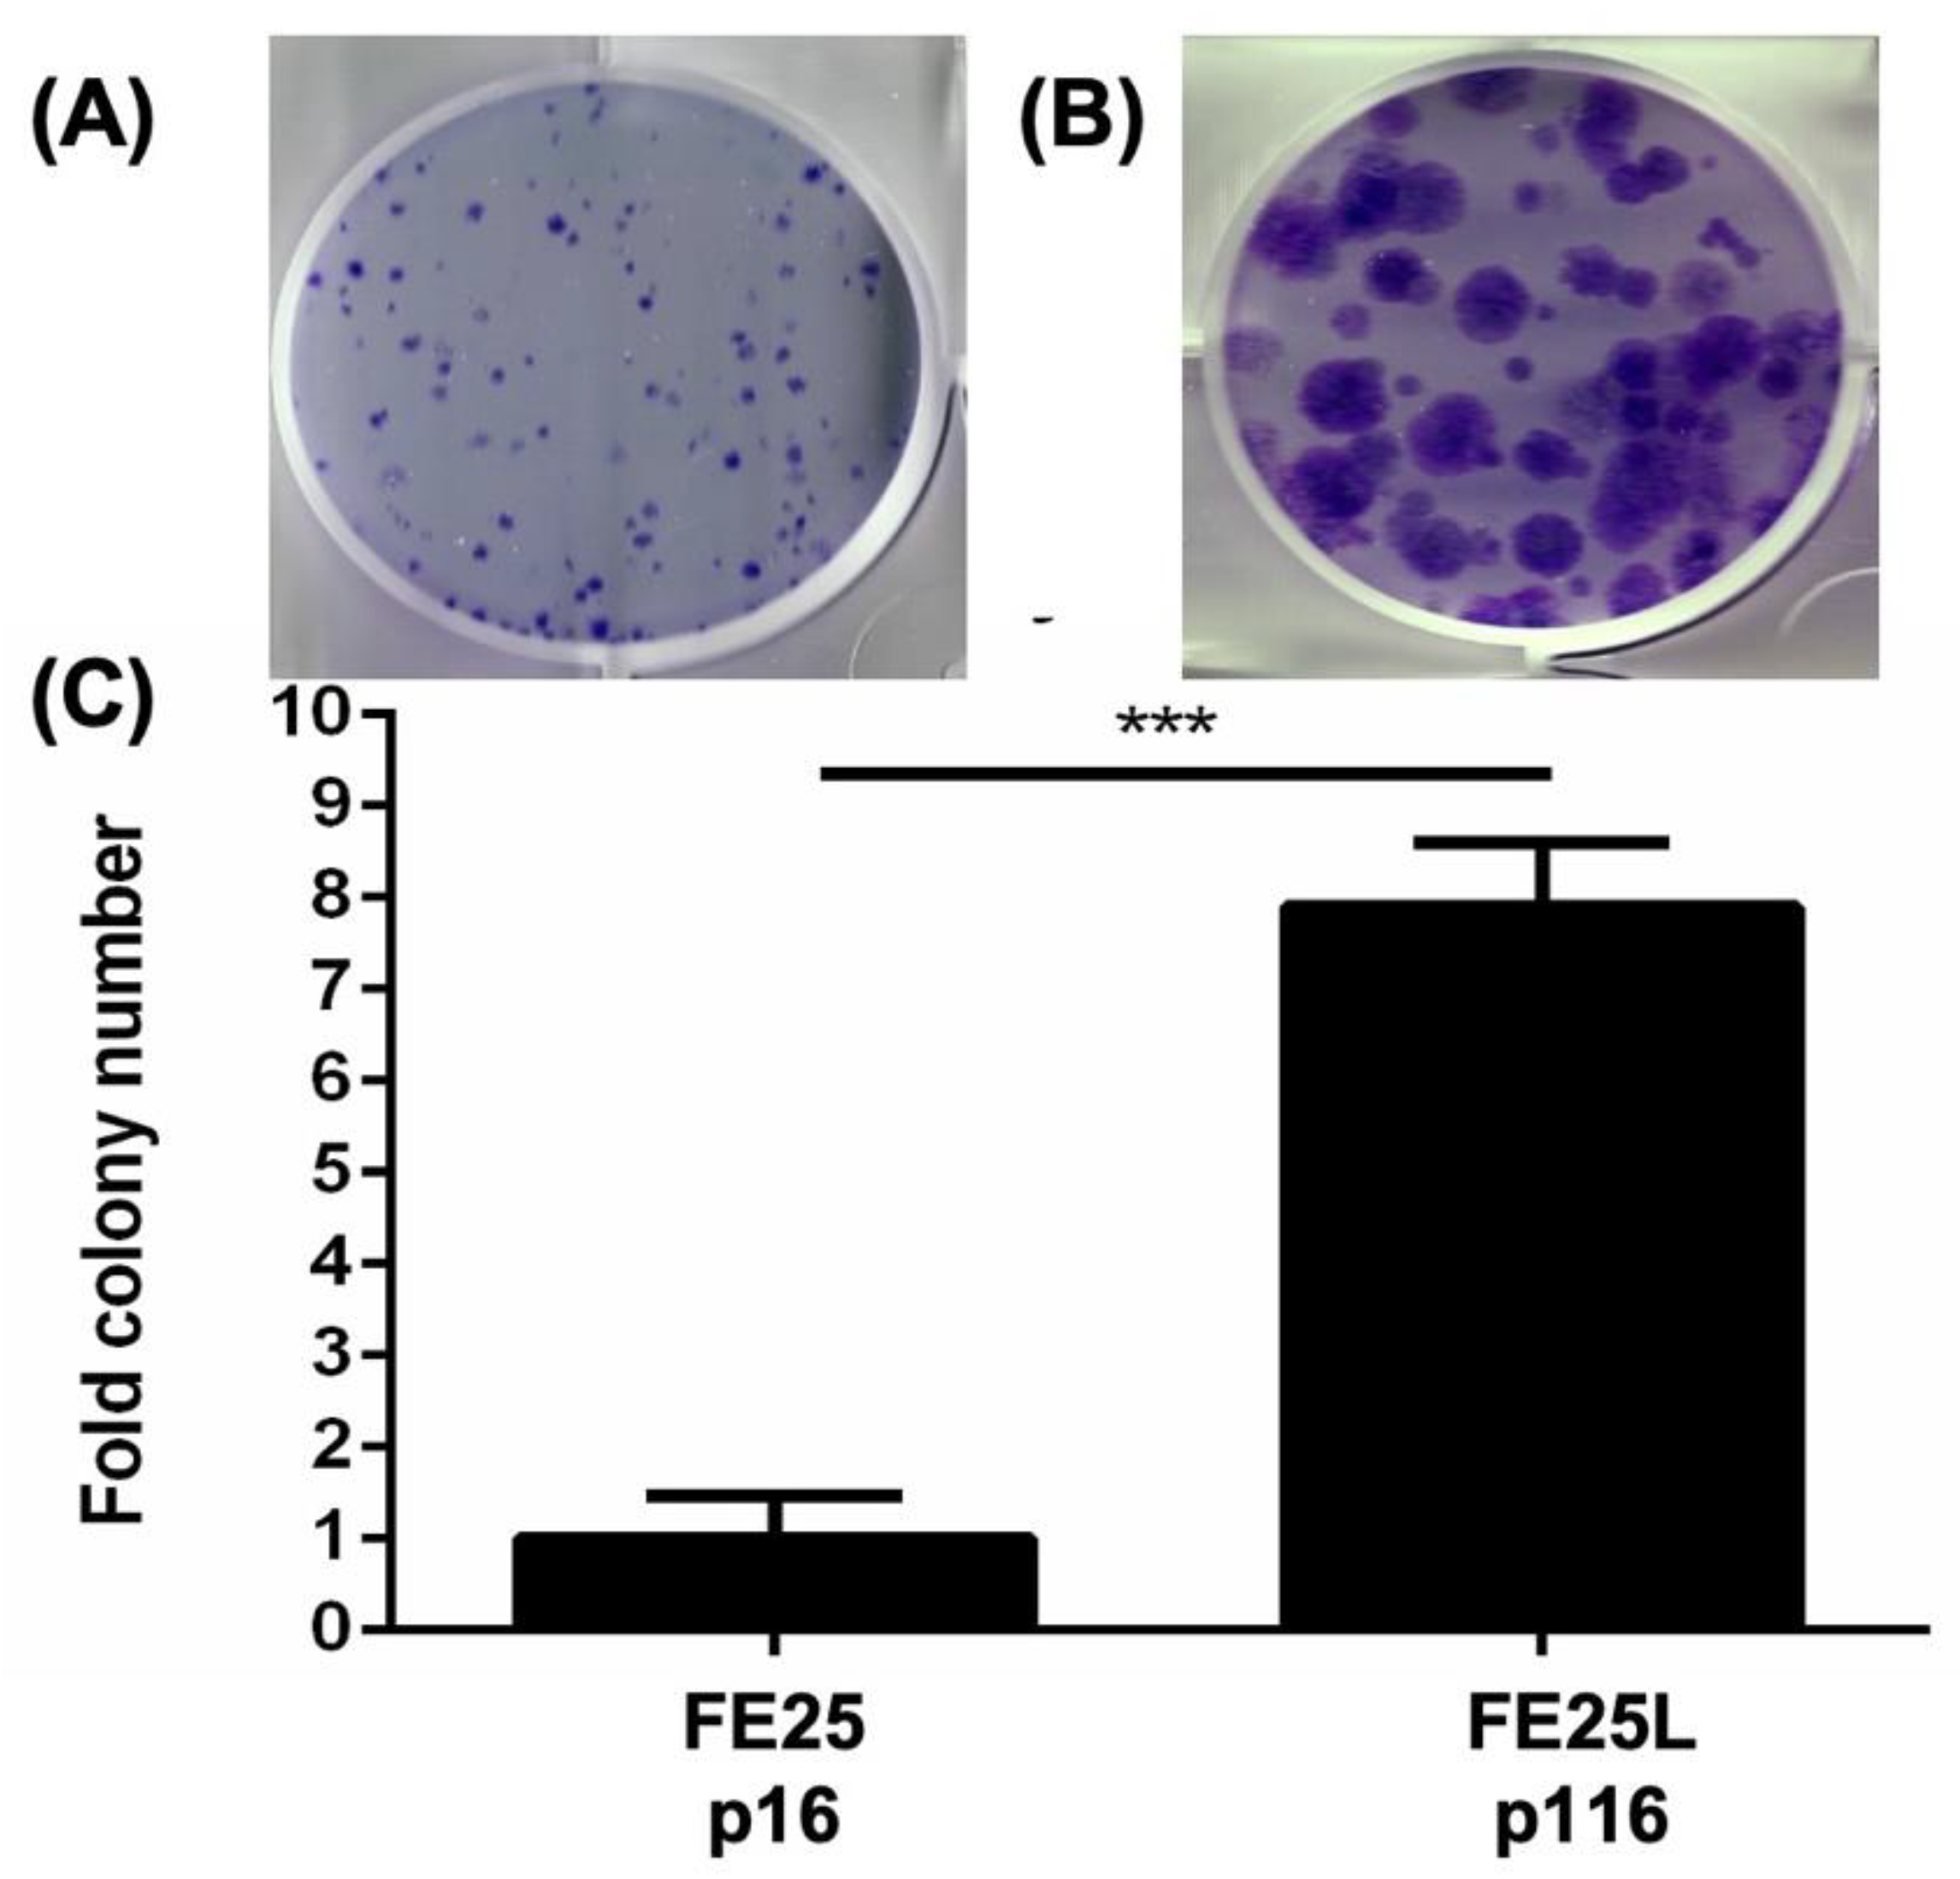
Ijms 23 13843 g003

Spontaneous Transformation of a p53 and Rb-Defective Human Fallopian Tube Epithelial Cell Line after Long Passage with Features of High-Grade Serous Carcinoma
Abstract
1. Introduction
2. Results
2.1. FE25L Cells Exhibited Faster Proliferation and More Cells in S and G2/M Phases
2.2. FE25L Had Higher Migration and Invasion Activity Than FE25 Cells
2.3. FE25L Formed More Colonies Than FE25 Cells
2.4. FE25L Exhibited Greater Tumorigenesis Potential
2.5. FE25L Acquired More Severe Aneuploidy
2.6. Copy Number Variation in FE25L vs. FE25
2.7. Differentially Regulated Gene Sets in FE25L Compared to FE25 Cells
2.8. FE25L Exhibited Higher Expression of EMT, Cytokine, NF-κB, and c-myc Signaling Pathways
2.9. FE25L Cells Exhibited Increased Wnt/β-Catenin Expression
2.10. FE25L Cells Are More Sensitive to Chemotherapeutic Drugs
2.11. Correlation of Gene Expression between FE25 and FE25L Cells and Current HGSOC Lines
3. Discussion
4. Materials and Methods
4.1. Cell Culture
4.2. Cell Proliferation Assay
4.3. Cell Cycle Analysis
4.4. Chromosome Evaluation
4.5. Colony Formation Assay
4.6. Migration and Invasion Assay
4.7. Drug Sensitivity Analysis
4.8. Gene Expression Analysis by qRT-PCR
Extraction of Total RNA from Cells
4.9. Preparation of cDNA
Quantitative Polymerase Chain Reaction
4.10. RNA Sequencing and Gene Set Enrichment Analysis (GSEA)
4.11. Cross-Platform Comparability
4.12. Library Preparation for the Whole Exon Sequencing
4.13. Copy Number Detection and Visualization
4.14. Western Blot
4.15. Xenograft Tumorigenesis
4.16. Immunohistochemistry (IHC)
4.17. Statistical Analysis
5. Conclusions
Author Contributions
Funding
Institutional Review Board Statement
Informed Consent Statement
Data Availability Statement
Acknowledgments
Conflicts of Interest
References
- Reid, B.M.; Permuth, J.B.; Sellers, T.A. Epidemiology of Ovarian Cancer: A Review. Cancer Biol. Med. 2017, 14, 9–32. [Google Scholar] [PubMed]
- Zhang, Y.; Luo, G.; Li, M.; Guo, P.; Xiao, Y.; Ji, H.; Hao, Y. Global patterns and trends in ovarian cancer incidence: Age, period and birth cohort analysis. BMC Cancer 2019, 19, 984. [Google Scholar] [CrossRef]
- O’Cearbhaill, R.E. Using PARP Inhibitors in Advanced Ovarian Cancer. Oncology 2018, 32, 339–343. [Google Scholar] [PubMed]
- Kurman, R.J.; Shih, I.-M. The Dualistic Model of Ovarian Carcinogenesis: Revisited, Revised, and Expanded. Am. J. Pathol. 2016, 186, 733–747. [Google Scholar] [CrossRef] [PubMed]
- Kurman, R.J.; Shih, I.-M. The Origin and Pathogenesis of Epithelial Ovarian Cancer: A Proposed Unifying Theory. Am. J. Surg. Pathol. 2010, 34, 433–443. [Google Scholar] [CrossRef]
- Zhang, Y.; Cao, L.; Nguyen, D.; Lu, H. TP53 mutations in epithelial ovarian cancer. Transl. Cancer Res. 2016, 5, 650–663. [Google Scholar] [CrossRef]
- Hoogstraat, M.; de Pagter, M.S.; Cirkel, G.A.; van Roosmalen, M.J.; Harkins, T.T.; Duran, K.; Kreeftmeijer, J.; Renkens, I.; Witteveen, P.O.; Lee, C.C.; et al. Genomic and transcriptomic plasticity in treatment-naïve ovarian cancer. Genome Res. 2014, 24, 200–211. [Google Scholar] [CrossRef]
- Etemadmoghadam, D.; Weir, B.A.; Au-Yeung, G.; Alsop, K.; Mitchell, G.; George, J.; Australian Ovarian Cancer Study Group; Davis, S.; D’Andrea, A.D.; Simpson, K.; et al. Synthetic lethality between CCNE1 amplification and loss of BRCA1. Proc. Natl. Acad. Sci. USA 2013, 110, 19489–19494. [Google Scholar] [CrossRef]
- Chen, J. The Cell-Cycle Arrest and Apoptotic Functions of p53 in Tumor Initiation and Progression. Cold Spring Harb. Perspect. Med. 2016, 6, a026104. [Google Scholar] [CrossRef]
- Levanon, K.; Crum, C.; Drapkin, R. New Insights Into the Pathogenesis of Serous Ovarian Cancer and Its Clinical Impact. J. Clin. Oncol. 2008, 26, 5284–5293. [Google Scholar] [CrossRef]
- Crum, C.P.; Drapkin, R.; Miron, A.; Ince, T.A.; Muto, M.; Kindelberger, D.W.; Lee, Y. The distal fallopian tube: A new model for pelvic serous carcinogenesis. Curr. Opin. Obstet. Gynecol. 2007, 19, 3–9. [Google Scholar] [CrossRef] [PubMed]
- Hsu, C.-F.; Huang, H.-S.; Chen, P.-C.; Ding, D.-C.; Chu, T.-Y. IGF-axis confers transformation and regeneration of fallopian tube fimbria epithelium upon ovulation. eBioMedicine 2019, 41, 597–609. [Google Scholar] [CrossRef]
- Karst, A.M.; Levanon, K.; Drapkin, R. Modeling high-grade serous ovarian carcinogenesis from the fallopian tube. Proc. Natl. Acad. Sci. USA 2011, 108, 7547–7552. [Google Scholar] [CrossRef] [PubMed]
- Karst, A.M.; Jones, P.M.; Vena, N.; Ligon, A.H.; Liu, J.F.; Hirsch, M.S.; Etemadmoghadam, D.; Bowtell, D.D.; Drapkin, R. Cyclin E1 Deregulation Occurs Early in Secretory Cell Transformation to Promote Formation of Fallopian Tube–Derived High-Grade Serous Ovarian Cancers. Cancer Res. 2014, 74, 1141–1152. [Google Scholar] [CrossRef] [PubMed]
- Graf, R.P.; Eskander, R.; Brueggeman, L.; Stupack, D.G. Association of Copy Number Variation Signature and Survival in Patients With Serous Ovarian Cancer. JAMA Netw. Open 2021, 4, e2114162. [Google Scholar] [CrossRef]
- The Cancer Genome Atlas Research Network. Integrated Genomic Analyses of Ovarian Carcinoma. Nature 2011, 474, 609–615. [Google Scholar] [CrossRef]
- Voutsadakis, I.A. 8p11.23 Amplification in Breast Cancer: Molecular Characteristics, Prognosis and Targeted Therapy. J. Clin. Med. 2020, 9, 3079. [Google Scholar] [CrossRef]
- Al-Achkar, W.; Wafa, A.; Moassass, F.; Liehr, T. A chronic myeloid leukemia case with a unique variant Philadelphia translocation: T(9;22;21)(q34;q11;p12). Oncol. Lett. 2012, 3, 1027–1029. [Google Scholar] [CrossRef]
- Subramanian, A.; Tamayo, P.; Mootha, V.K.; Mukherjee, S.; Ebert, B.L.; Gillette, M.A.; Paulovich, A.; Pomeroy, S.L.; Golub, T.R.; Lander, E.S.; et al. Gene set enrichment analysis: A knowledge-based approach for interpreting genome-wide expression profiles. Proc. Natl. Acad. Sci. USA 2005, 102, 15545–15550. [Google Scholar] [CrossRef]
- Sohn, M.-H.; Kim, S.; Shin, J.-Y.; Kim, H.; Chung, H.; Kim, J.-W.; Lee, M.; Seo, J.-S. Classification of High-Grade Serous Ovarian Carcinoma by Epithelial-to-Mesenchymal Transition Signature and Homologous Recombination Repair Genes. Genes 2021, 12, 1103. [Google Scholar] [CrossRef]
- Worzfeld, T.; Von Strandmann, E.P.; Huber, M.; Adhikary, T.; Wagner, U.; Reinartz, S.; Müller, R. The Unique Molecular and Cellular Microenvironment of Ovarian Cancer. Front. Oncol. 2017, 7, 24. [Google Scholar] [CrossRef] [PubMed]
- Hashimoto, T.; Yanaihara, N.; Okamoto, A.; Nikaido, T.; Saito, M.; Takakura, S.; Yasuda, M.; Sasaki, H.; Ochiai, K.; Tanaka, T. Cyclin D1 predicts the prognosis of advanced serous ovarian cancer. Exp. Ther. Med. 2011, 2, 213–219. [Google Scholar] [CrossRef] [PubMed][Green Version]
- Ghoneum, A.; Abdulfattah, A.Y.; Said, N. Targeting the PI3K/AKT/mTOR/NFκB Axis in Ovarian Cancer. J. Cell. Immunol. 2020, 2, 68–73. [Google Scholar] [PubMed]
- McCloskey, C.W.; Goldberg, R.L.; Carter, L.E.; Gamwell, L.F.; Al-Hujaily, E.M.; Collins, O.; Macdonald, E.A.; Garson, K.; Daneshmand, M.; Carmona, E.; et al. A New Spontaneously Transformed Syngeneic Model of High-Grade Serous Ovarian Cancer with a Tumor-Initiating Cell Population. Front. Oncol. 2014, 4, 53. [Google Scholar] [CrossRef] [PubMed]
- Zeng, M.; Kwiatkowski, N.P.; Zhang, T.; Nabet, B.; Xu, M.; Liang, Y.; Quan, C.; Wang, J.; Hao, M.; Palakurthi, S.; et al. Targeting MYC Dependency in Ovarian Cancer through Inhibition of CDK7 and CDK12/13. eLife 2018, 7, e39030. [Google Scholar] [CrossRef] [PubMed]
- Nguyen, V.H.L.; Hough, R.; Bernaudo, S.; Peng, C. Wnt/β-catenin signalling in ovarian cancer: Insights into its hyperactivation and function in tumorigenesis. J. Ovarian Res. 2019, 12, 122. [Google Scholar] [CrossRef] [PubMed]
- Domcke, S.; Sinha, R.; Levine, D.A.; Sander, C.; Schultz, N. Evaluating cell lines as tumour models by comparison of genomic profiles. Nat. Commun. 2013, 4, 2126. [Google Scholar] [CrossRef]
- Huang, H.-S.; Chu, S.-C.; Hsu, C.-F.; Chen, P.-C.; Ding, D.-C.; Chang, M.-Y.; Chu, T.-Y. Mutagenic, surviving and tumorigenic effects of follicular fluid in the context of p53 loss: Initiation of fimbria carcinogenesis. Carcinogenesis 2015, 36, 1419–1428. [Google Scholar] [CrossRef]
- Huang, H.-S.; Hsu, C.-F.; Chu, S.-C.; Chen, P.-C.; Ding, D.-C.; Chang, M.-Y.; Chu, T.-Y. Haemoglobin in pelvic fluid rescues Fallopian tube epithelial cells from reactive oxygen species stress and apoptosis. J. Pathol. 2016, 240, 484–494. [Google Scholar] [CrossRef]
- Perets, R.; Wyant, G.A.; Muto, K.W.; Bijron, J.G.; Poole, B.B.; Chin, K.T.; Chen, J.Y.H.; Ohman, A.W.; Stepule, C.D.; Kwak, S.; et al. Transformation of the Fallopian Tube Secretory Epithelium Leads to High-Grade Serous Ovarian Cancer in Brca;Tp53;Pten Models. Cancer Cell 2013, 24, 751–765. [Google Scholar] [CrossRef]
- Huang, H.-S.; Chen, P.-C.; Chu, S.-C.; Lee, M.-H.; Huang, C.-Y.; Chu, T.-Y. Ovulation sources coagulation protease cascade and hepatocyte growth factor to support physiological growth and malignant transformation. Neoplasia 2021, 23, 1123–1136. [Google Scholar] [CrossRef] [PubMed]
- Hsu, C.-F.; Chen, P.-C.; Seenan, V.; Ding, D.-C.; Chu, T.-Y. Ovulatory Follicular Fluid Facilitates the Full Transformation Process for the Development of High-Grade Serous Carcinoma. Cancers 2021, 13, 468. [Google Scholar] [CrossRef] [PubMed]
- Mei, J.; Tian, H.; Huang, H.; Hsu, C.; Liou, Y.; Wu, N.; Zhang, W.; Chu, T. Cellular models of development of ovarian high-grade serous carcinoma: A review of cell of origin and mechanisms of carcinogenesis. Cell Prolif. 2021, 54, e13029. [Google Scholar] [CrossRef]
- Roby, K.F.; Taylor, C.C.; Sweetwood, J.P.; Cheng, Y.; Pace, J.L.; Tawfik, O.; Persons, D.L.; Smith, P.G.; Terranova, P.F. Development of a syngeneic mouse model for events related to ovarian cancer. Carcinogenesis 2000, 21, 585–591. [Google Scholar] [CrossRef]
- Quartuccio, S.M.; Lantvit, D.D.; Bosland, M.C.; Burdette, J.E. Conditional Inactivation of p53 in Mouse Ovarian Surface Epithelium Does Not Alter MIS Driven Smad2-Dominant Negative Epithelium-Lined Inclusion Cysts or Teratomas. PLoS ONE 2013, 8, e65067. [Google Scholar] [CrossRef]
- Bachmann, I.M.; Halvorsen, O.J.; Collett, K.; Stefansson, I.M.; Straume, O.; Haukaas, S.A.; Salvesen, H.B.; Otte, A.P.; Akslen, L.A. EZH2 expression is associated with high proliferation rate and aggressive tumor subgroups in cutaneous melanoma and cancers of the endometrium, prostate, and breast. J. Clin. Oncol. 2006, 24, 268–273. [Google Scholar] [CrossRef]
- Mouriaux, F.; Zaniolo, K.; Bergeron, M.-A.; Weidmann, C.; de la Fouchardiere, A.; Fournier, F.; Droit, A.; Morcos, M.W.; Landreville, S.; Guérin, S.L. Effects of Long-term Serial Passaging on the Characteristics and Properties of Cell Lines Derived From Uveal Melanoma Primary Tumors. Investig. Opthalmol. Vis. Sci. 2016, 57, 5288–5301. [Google Scholar] [CrossRef]
- Burrell, R.A.; McClelland, S.E.; Endesfelder, D.; Groth, P.; Weller, M.-C.; Shaikh, N.; Domingo, E.; Kanu, N.; Dewhurst, S.M.; Gronroos, E.; et al. Replication stress links structural and numerical cancer chromosomal instability. Nature 2013, 494, 492–496. [Google Scholar] [CrossRef] [PubMed]
- Vargas-Rondón, N.; Villegas, V.E.; Rondón-Lagos, M. The Role of Chromosomal Instability in Cancer and Therapeutic Responses. Cancers 2017, 10, 4. [Google Scholar] [CrossRef]
- Weberpals, J.I.; Clark-Knowles, K.V.; Vanderhyden, B.C. Sporadic Epithelial Ovarian Cancer: Clinical Relevance of BRCA1 Inhibition in the DNA Damage and Repair Pathway. J. Clin. Oncol. 2008, 26, 3259–3267. [Google Scholar] [CrossRef]
- Amfo, K.; Neyns, B.; Teugels, E.; Lissens, W.; Bourgain, C.; De Sutter, P.; Vandamme, B.; Vamos, E.; De Greve, J. Frequent deletion of chromosome 19 and a rare rearrangement of 19p13.3 involving the insulin receptor gene in human ovarian cancer. Oncogene 1995, 11, 351–358. [Google Scholar] [PubMed]
- Delaney, J.R.; Patel, C.B.; Willis, K.M.; Haghighiabyaneh, M.; Axelrod, J.; Tancioni, I.; Lu, D.; Bapat, J.; Young, S.; Cadassou, O.; et al. Haploinsufficiency networks identify targetable patterns of allelic deficiency in low mutation ovarian cancer. Nat. Commun. 2017, 8, 14423. [Google Scholar] [CrossRef] [PubMed]
- Schwarz, R.; Ng, C.K.Y.; Cooke, S.L.; Newmann, S.; Temple, J.; Piskorz, A.M.; Gale, D.; Sayal, K.; Murtaza, M.; Baldwin, P.J.; et al. Spatial and Temporal Heterogeneity in High-Grade Serous Ovarian Cancer: A Phylogenetic Analysis. PLoS Med. 2015, 12, e1001789. [Google Scholar] [CrossRef] [PubMed]
- Slamon, D.J.; Godolphin, W.; Jones, L.A.; Holt, J.A.; Wong, S.G.; Keith, D.E.; Levin, W.J.; Stuart, S.G.; Udove, J.; Ullrich, A. Studies of the HER-2/neu Proto-Oncogene in Human Breast and Ovarian Cancer. Science 1989, 244, 707–712. [Google Scholar] [CrossRef]
- Mayr, D.; Kanitz, V.; Anderegg, B.; Luthardt, B.; Engel, J.; Löhrs, U.; Amann, G.; Diebold, J. Analysis of Gene Amplification and Prognostic Markers in Ovarian Cancer Using Comparative Genomic Hybridization for Microarrays and Immunohistochemical Analysis for Tissue Microarrays. Am. J. Clin. Pathol. 2006, 126, 101–109. [Google Scholar] [CrossRef]
- Delaney, J.R.; Stupack, D.G. Genomic Copy Number Alterations in Serous Ovarian Cancer. In Ovarian Cancer—From Pathogenesis to Treatment; Devaja, O., Papadopoulos, A., Eds.; IntechOpen: London, UK, 2018; ISBN 9781789843347. [Google Scholar]
- Feng, Q.; Li, P.; Salamanca, C.; Huntsman, D.; Leung, P.C.; Auersperg, N. Caspase-1α Is Down-regulated in Human Ovarian Cancer Cells and the Overexpression of Caspase-1α Induces Apoptosis. Cancer Res. 2005, 65, 8591–8596. [Google Scholar] [CrossRef][Green Version]
- Zhang, K.; Kong, X.; Feng, G.; Xiang, W.; Chen, L.; Yang, F.; Cao, C.; Ding, Y.; Chen, H.; Chu, M.; et al. Investigation of hypoxia networks in ovarian cancer via bioinformatics analysis. J. Ovarian Res. 2018, 11, 16. [Google Scholar] [CrossRef]
- Yang, J.; Antin, P.; Berx, G.; Blanpain, C.; Brabletz, T.; Bronner, M.; Campbell, K.; Cano, A.; Casanova, J.; Christofori, G.; et al. Guidelines and definitions for research on epithelial–mesenchymal transition. Nat. Rev. Mol. Cell Biol. 2020, 21, 341–352. [Google Scholar] [CrossRef]
- Koutsaki, M.; Spandidos, D.; Zaravinos, A. Epithelial–mesenchymal transition-associated miRNAs in ovarian carcinoma, with highlight on the miR-200 family: Prognostic value and prospective role in ovarian cancer therapeutics. Cancer Lett. 2014, 351, 173–181. [Google Scholar] [CrossRef]
- Takai, M.; Terai, Y.; Kawaguchi, H.; Ashihara, K.; Fujiwara, S.; Tanaka, T.; Tsunetoh, S.; Tanaka, Y.; Sasaki, H.; Kanemura, M.; et al. The EMT (epithelial-mesenchymal-transition)-related protein expression indicates the metastatic status and prognosis in patients with ovarian cancer. J. Ovarian Res. 2014, 7, 76. [Google Scholar] [CrossRef]
- Matte, I.; Lane, D.; Laplante, C.; Rancourt, C.; Piché, A. Profiling of cytokines in human epithelial ovarian cancer ascites. Am. J. Cancer Res. 2012, 2, 566–580. [Google Scholar] [PubMed]
- Ding, D.-C.; Liu, H.-W.; Chu, T.-Y. Interleukin-6 from Ovarian Mesenchymal Stem Cells Promotes Proliferation, Sphere and Colony Formation and Tumorigenesis of an Ovarian Cancer Cell Line SKOV3. J. Cancer 2016, 7, 1815–1823. [Google Scholar] [CrossRef] [PubMed]
- To, S.K.Y.; Mak, A.S.C.; Fung, Y.M.E.; Che, C.-M.; Li, S.-S.; Deng, W.; Ru, B.; Zhang, J.; Wong, A.S.T. β-catenin downregulates Dicer to promote ovarian cancer metastasis. Oncogene 2017, 36, 5927–5938. [Google Scholar] [CrossRef] [PubMed]
- Cao, P.; Zhao, S.; Sun, Z.; Jiang, N.; Shang, Y.; Wang, Y.; Gu, J.; Li, S. BRMS1L suppresses ovarian cancer metastasis via inhibition of the β-catenin-wnt pathway. Exp. Cell Res. 2018, 371, 214–221. [Google Scholar] [CrossRef] [PubMed]
- Tahtamouni, L.; Ahram, M.; Koblinski, J.; Rolfo, C. Molecular Regulation of Cancer Cell Migration, Invasion, and Metastasis. Anal. Cell. Pathol. 2019, 2019, 1356508. [Google Scholar] [CrossRef]
- Gamarra-Luques, C.D.; Hapon, M.B.; Goyeneche, A.A.; Telleria, C.M. Resistance to cisplatin and paclitaxel does not affect the sensitivity of human ovarian cancer cells to antiprogestin-induced cytotoxicity. J. Ovarian Res. 2014, 7, 45. [Google Scholar] [CrossRef]
- Pokhriyal, R.; Hariprasad, R.; Kumar, L.; Hariprasad, G. Chemotherapy Resistance in Advanced Ovarian Cancer Patients. Biomark. Cancer 2019, 11, 1179299X19860815. [Google Scholar] [CrossRef]
- Nicholson, J.M.; Cimini, D. Cancer Karyotypes: Survival of the Fittest. Front. Oncol. 2013, 3, 148. [Google Scholar] [CrossRef]
- Cristea, M.; Han, E.; Salmon, L.; Morgan, J.R.J. Review: Practical considerations in ovarian cancer chemotherapy. Ther. Adv. Med. Oncol. 2010, 2, 175–187. [Google Scholar] [CrossRef]
- Talevich, E.; Shain, A.H.; Botton, T.; Bastian, B.C. CNVkit: Genome-Wide Copy Number Detection and Visualization from Targeted DNA Sequencing. PLoS Comput. Biol. 2016, 12, e1004873. [Google Scholar] [CrossRef]
- Gallo-Oller, G.; Ordoñez, R.; Dotor, J. A new background subtraction method for Western blot densitometry band quantification through image analysis software. J. Immunol. Methods 2018, 457, 1–5. [Google Scholar] [CrossRef] [PubMed]

| Gene Set Name [# Genes (K)] | Description | # Genes in Overlap (k) | p-Value | FDR q-Value |
|---|---|---|---|---|
| NIKOLSKY_BREAST_ CANCER_7Q21_Q22_AMPLIC | Genes within amplicon 7q21–q22 identified in a copy number alterations study of 191 breast tumor samples. | ARPC1A, PDAP1, ATP5MF, BUD31, ARPC1B, BAIAP2L1, SMURF1, ZKSCAN5, TRRAP, PTCD1, FAM200A, CPSF4, ZNF789, ZNF394, NPTX2, TMEM130, LMTK2, BRI3, TECPR1, BHLHA15 | 1.97 × 10−37 | 6.37 × 10−33 |
| chr18p11 <201> | Ensembl 103 genes in cytogenetic band chr18p11 | RAB31, RALBP1, VAPA, NDUFV2, PPP4R1, TWSG1, PTPRM, MTCL1, ANKRD12, GNAL, RAB12, NAPG, LRRC30, APCDD1, NDUFV2-AS1, PIEZO2, TXNDC2, MIR7153, MIR6788, SLC35G4 | 3.62 × 10−28 | 5.85 × 10−24 |
| chr7q22 <213> | Ensembl 103 genes in cytogenetic band chr7q22 | ARPC1A, PDAP1, ATP5MF, BUD31, ARPC1B, BAIAP2L1, SMURF1, ZKSCAN5, TRRAP, PTCD1, FAM200A, CPSF4, ZNF789, ZNF394, NPTX2, TMEM130, ATP5MF-PTCD1, KPNA7, MYH16, MIR3609 | 1.2 × 10−27 | 1.29 × 10−23 |
| chr2p25 <117> | Ensembl 103 genes in cytogenetic band chr2p25 | ACP1, FAM110C, SNTG2, TPO, SH3YL1, TMEM18, ALKAL2 | 5.92 × 10−9 | 4.78 × 10−5 |
| chr20q11 <237> | Ensembl 103 genes in cytogenetic band chr20q11 | DNMT3B, MAPRE1, COMMD7, AL034550.2, NOL4L, EFCAB8, C20orf203, NOL4L-DT | 4.13 × 10−8 | 2.67 × 10−4 |
| DIAZ_CHRONIC_ MEYLOGENOUS_LEUKEMIA_UP <1398> | Genes up-regulated in CD34+ [GeneID = 947] cells isolated from bone marrow of CML (chronic myelogenous leukemia) patients, compared to those from normal donors. (chr7) | ARPC1A, PDAP1, ATP5MF, RAB31, RALBP1, VAPA, NDUFV2, PPP4R1, TWSG1, FAM110C, DNMT3B, URI1, ZMYND11 | 7.21 × 10−6 | 3.88 × 10−2 |
| Gene Set Name [# Genes (K)] | Description | # Genes in Overlap (k) | p-Value | FDR q-Value |
|---|---|---|---|---|
| HALLMARK_ COMPLEMENT <200> | Genes encoding components of the complement system, which is part of the innate immune system. | SERPING1, MMP8, S100A13, FDX1, CTSC, CASP1, CASP4, S100A9, EHD1, APOA4, MMP12, MMP13, PRCP, S100A12, CASP5, RCE1 | 1.99 × 10−4 | 9.95 × 10−3 |
| HALLMARK_ COAGULATION <138> | Genes encoding components of blood coagulation system; also up-regulated in platelets. | SERPING1, MMP8, S100A13, PRSS23, S100A1, MMP1, MMP3, MMP10, APOA1, CAPN5, APOC3, MMP7 | 5.75 × 10−4 | 1.44 × 10−2 |
| HALLMARK_OXIDATIVE_PHOSPHORYLATION <200> | Genes encoding proteins involved in oxidative phosphorylation. | FDX1, COX8A, DLAT, CPT1A, SDHD, TCIRG1, ATP5MG, TIMM10, TIMM8B, ACAT1, NDUFC2, NDUFV1, NDUFS8, MRPL11 | 1.77 × 10−3 | 2.95 × 10−2 |
| HALLMARK_ESTROGEN_ RESPONSE_EARLY <200> | Genes defining early response to estrogen. | PRSS23, DHCR7, CCND1, PLAAT3, ALDH3B1, PGR, ENDOD1, P2RY2, TSKU, RHOD, NADSYN1, SYT12, GAB2 | 4.77 × 10−3 | 4.77 × 10−2 |
| HALLMARK_MTORC1_ SIGNALING <200> | Genes up-regulated through activation of mTORC1 complex. | CTSC, DHCR7, SC5D, FADS2, TM7SF2, SERPINH1, RPA1, HMBS, STIP1, FADS1, SLC37A4, FKBP2, SYTL2 | 4.77 × 10−3 | 4.77 × 10−2 |
| Gene Set Name [# Genes (K)] | Description | Genes in Overlap | FDR q-Value |
|---|---|---|---|
| HALLMARK_HYPOXIA | Genes up-regulated in response to low oxygen levels (hypoxia). | VEGFA, CDKN1A, BTG1, NDRG1, DDIT3, DDIT4, ADORA2B, NR3C1, MXI1, ADM, SRPX, HOXB9 | 5.42 × 10−12 |
| HALLMARK_EPITHELIAL_ MESENCHYMAL_TRANSI NSITION | Genes defining epithelial-mesenchymal transition, as in wound healing, fibrosis, and metastasis. | VEGFA, COL6A2, COL6A3, ADAM12, TFPI2, MXRA5, LAMA1, SERPINE2, SFRP1 | 3.14 × 10−8 |
| HALLMARK_TNFA_SIGNALING_VIA_NFKB | Genes regulated by NF-κB in response to TNF | VEGFA, CDKN1A, BTG1, PHLDA1, ETS2, ABCA1, DUSP5, EGR1, MSC | 3.14 × 10−8 |
| HALLMARK_P53_PATHWAY | Genes involved in p53 pathways and networks. | CDKN1A, BTG1, NDRG1, DDIT3, DDIT4, TRIB3, F2R, UPP1 | 4.86 × 10−7 |
| HALLMARK_IL2_STAT5_SIGNALING | Genes up-regulated by STAT5 in response to IL2 stimulation. | NDRG1, PHLDA1, NRP1, LRIG1, F2RL2, PLAGL1, SCN9A | 6.78 × 10−6 |
| HALLMARK_PI3K_AKT_MTOR_ SIGNALING | Genes up-regulated by activation of the PI3K/AKT/mTOR pathway. | CDKN1A, DDIT3, TRIB3, CALR, CAMK4 | 5.5 × 10−5 |
| HALLMARK_MTORC1_SIGNALING | Genes up-regulated through activation of mTORC1 complex. | CDKN1A, DDIT3, DDIT4, TRIB3, CALR, NIBAN1 | 7.8 × 10−5 |
| HALLMARK_ANGIOGENESIS | Genes up-regulated during formation of blood vessels (angiogenesis). | VEGFA, NRP1, FGFR1 | 5.47 × 10−4 |
| HALLMARK_HEDGEHOG_SIGNALING | Genes up-regulated by activation of hedgehog signaling. | VEGFA, ETS2, NRP1 | 5.47 × 10−4 |
| HALLMARK_UNFOLDED_PROTEIN_ RESPONSE | Genes up-regulated during unfolded protein response, a cellular stress response related to the endoplasmic reticulum. | VEGFA, DDIT4, CALR, HYOU1 | 9.18 × 10−4 |
| HALLMARK_UV_RESPONSE_DN | Genes down-regulated in response to ultraviolet (UV) radiation. | ADORA2B, NR3C1, NRP1, BCL2L11 | 2.1 × 10−3 |
| HALLMARK_APOPTOSIS | Genes mediating programmed cell death (apoptosis) by activation of caspases. | CDKN1A, DDIT3, F2R, BCL2L11 | 2.93 × 10−3 |
| HALLMARK_CHOLESTEROL_ HOMEOSTASIS | Genes involved in cholesterol homeostasis. | TRIB3, NIBAN1, CBS | 3.21 × 10−3 |
| HALLMARK_GLYCOLYSIS | Genes encoding proteins involved in glycolysis and gluconeogenesis. | VEGFA, DDIT4, ADORA2B, MXI1 | 4.89 × 10−3 |
| HALLMARK_INFLAMMATORY_ RESPONSE | Genes defining inflammatory response. | CDKN1A, ADORA2B, ADM | 4.89 × 10−3 |
| HALLMARK_MYOGENESIS | Genes involved in development of skeletal muscle (myogenesis). | CDKN1A, COL6A2, COL6A3, ADAM12 | 4.89 × 10−3 |
| HALLMARK_MITOTIC_SPINDLE | Genes important for mitotic spindle assembly. | BCL2L11, CLIP2, ARHGEF2 | 3.07 × 10−2 |
| HALLMARK_ESTROGEN_RESPONSE_ EARLY | Genes defining early response to estrogen. | LRIG1, ELOVL2, MLPH | 3.07 × 10−2 |
| HALLMARK_HEME_METABOLISM | Genes involved in metabolism of heme (a cofactor consisting of iron and porphyrin) and erythroblast differentiation. | NR3C1, MXI1, SLC6A9 | 3.07 × 10−2 |
| HALLMARK_INTERFERON_GAMMA_ RESPONSE | Genes up-regulated in response to IFNG | CDKN1A, BTG1, UPP1 | 3.07 × 10−2 |
| HALLMARK_XENOBIOTIC_ METABOLISM | Genes encoding proteins involved in processing of drugs and other xenobiotics. | ETS2, UPP1, AKR1C3 | 3.07 × 10−2 |
| Gene Set Name [# Genes (K)] | Description | Genes in Overlap | FDR q-Value |
|---|---|---|---|
| HALLMARK_INTERFERON_GAMMA_ RESPONSE | Genes up-regulated in response to IFNG | IFI44L, MX1, TXNIP, IFI44, USP18, IFI27, HERC6, EPSTI1, ISG15, CFH, IFIT1, MX2, OAS2, OAS3 | 4.24 × 10−15 |
| HALLMARK_INTERFERON_ALPHA_ RESPONSE | Genes up-regulated in response to alpha-interferon proteins. | IFI44L, MX1, TXNIP, IFI44, USP18, IFI27, HERC6, EPSTI1, ISG15, IFITM1, OAS1 | 2.19 × 10−14 |
| HALLMARK_EPITHELIAL_ MESENCHYMAL_TRANSI NSITION | Genes defining epithelial-mesenchymal transition, as in wound healing, fibrosis, and metastasis. | TIMP3, THBS1, COL3A1, VCAN, COL4A2, IGFBP4, TAGLN, CDH6, COL1A2, APLP1, NTM | 4.64 × 10−11 |
| HALLMARK_COAGULATION | Genes encoding components of blood coagulation system; also up-regulated in platelets. | CFH, TIMP3, THBS1, OLR1, PDGFB, MMP15 | 1.52 × 10−5 |
| HALLMARK_ANGIOGENESIS | Genes are up-regulated during formation of blood vessels (angiogenesis). | VCAN, COL4A2, OLR1 | 8.58 × 10−4 |
| HALLMARK_COMPLEMENT | Genes encode components of the complement system, which is part of the innate immune system. | CFH, COL4A2, OLR1, PDGFB, MMP15 | 8.58 × 10−4 |
| HALLMARK_ESTROGEN_RESPONSE_ EARLY | Genes defining early response to estrogen. | IGFBP4, CCND1, KRT19, ITPK1, DHRS3 | 8.58 × 10−4 |
| HALLMARK_MYOGENESIS | Genes involved in development of skeletal muscle (myogenesis). | COL3A1, COL4A2, TAGLN, ITGB4, PTGIS | 8.58 × 10−4 |
| HALLMARK_APICAL_ JUNCTION | Genes encoding components of apical junction complex. | VCAN, CDH6, ITGB4, ACTG2 | 6.86 × 10−3 |
| HALLMARK_ESTROGEN_RESPONSE_ LATE | Genes defining late response to estrogen. | IGFBP4, CCND1, KRT19, ITPK1 | 6.86 × 10−3 |
| HALLMARK_KRAS_SIGNALING_DN | Genes down-regulated by KRAS activation. | IFI44L, MX1, SYNPO, TENM2 | 6.86 × 10−3 |
| HALLMARK_ANDROGEN_RESPONSE | Genes defining response to androgens. | CCND1, KRT19, ALDH1A3 | 8.05 × 10−3 |
| HALLMARK_UV_RESPONSE_DN | Genes down-regulated in response to ultraviolet (UV) radiation. | COL3A1, COL1A2, CELF2 | 2.07 × 10−2 |
| HALLMARK_APOPTOSIS | Genes mediating programmed cell death (apoptosis) by activation of caspases. | TXNIP, TIMP3, CCND1 | 2.62 × 10−2 |
| HALLMARK_P53_PATHWAY | Genes involved in p53 pathways and networks. | TXNIP, ITGB4, KRT17 | 4.39 × 10−2 |
| Gene | Sense (5′-3′) | Antisense (5′-3′) | Product Size (bp) |
|---|---|---|---|
| Ecad | CGGGAATGCAGTTGAGGATC | AGGATGGTGTAAGCGATGGC | 201 |
| Ncad | ACCAGGTTTGGAATGGGACA | ACATGTTGGGTGAAGGGGTG | 156 |
| Fibronectin | CAGTGGGAGACCTCGAGAAG | TCCCTCGGAACATCAGAAAC | 168 |
| Vimentin | GCATGTCCAAATCGATGTGG | ATTGTTCCGGTTGGCAGCCT | 163 |
| Twist | GGAGTCCGCAGTCTTACGAG | TCTGGAGGACCTGGTAGAGG | 201 |
| CXCL1 | AACCCCAAGTTAGTTCAATCTGGA | CATGTTGCAGGCTCCTCAGAA | 104 |
| CXCL2 | TCAAACCCAAGTTAGTTCAATCCTGA | GCTGACATGTGATATGTCATCACGAA | 113 |
| IL-6 | TACCCCCAGGAGAAGATTCC | TTTTCTGCCAGTGCCTCTTT | 175 |
| IL-8 | GACATACTCCAAACCTTTCCAC | TTCTCAGCCCTCTTCAAAAAC | 180 |
| BMP2 | AACACTGTGCGCAGCTTCC | CTCCGGGTTGTTTTCCCAC | 74 |
| TIMP1 | TCTGCAATTCCGACCTCGTCATCA | AAGGTGGTCTGGTTGACTTCTGGT | 67 |
| IGF2 | ACACCCTCCAGTTCGTCTGT | GGGGTATCTTGGGGAAGTTGT | 213 |
| VEGFA | CTACCTCCACCATGCCAAGT | GCAGTAGCTGCGCTGATAGA | 109 |
| CDKN2A | GTGGACCTGGCTGAGGAG | CTTTCAATCGGGGATGTCTG | 132 |
| SFRP1 | TTGAGCATTTGAAAGGTGTGCTA | ACAGCTACACTACCAGGGAAATCC | 121 |
| FRZB | CCTGCCCTGGAACATGACTAA | CAGACCTTCGAACTGCTCGAT | 91 |
| SFRP4 | TGTGTTACGAGTGGCG | GGGGGATTACTACGACTG | 172 |
| CCND1 | TCCTCTCCAAAATGCCAGAG | GGCGGATTGGAAATGAACTT | 109 |
| IKKe | ACTCTGGAAGTGGCAAGGACAT | TACCTGATCCCGGCTCTTCACCA | 234 |
| S100A4 | AGTTCAAGCTCAACAAGTCAGAACTAA | TCATCTGTCCTTTTCCCCAAGA | 79 |
| SPP1 | GCCAGTTGCAGCCTTCTCA | AAAAGCAAATCACTGCAATTCTCA | 75 |
| C-MYC | CCTGGTGCTCCATGAGGAGAC | CAGACTCTGACCTTTTGCCAGG | 128 |
| GNAL | CACCAGATGCAGGAGAAGATCC | AGGTGAAGTGCGGGTAGCAGTA | 120 |
| TMEM130 | GCTCCTATCTCACTAAGACCGTC | CACGGAGTCTTCAGTCACCATC | 134 |
| DNMT3B | TAACAACGGCAAAGACCGAGGG | TCCTGCCACAAGACAAACAGCC | 110 |
| CCND1 | TCCTCTCCAAAATGCCAGAG | GGCGGATTGGAAATGAACTT | 109 |
| CASP1 | GCTGAGGTTGACATCACAGGCA | TGCTGTCAGAGGTCTTGTGCTC | 145 |
| EHD1 | GCGTTTGGCAACGCTTTCCTCA | ATCCGCTGCTTCTCTCCAGACA | 116 |
| P2RY2 | CGAGGACTTCAAGTACGTGCTG | GTGGACGCATTCCAGGTCTTGA | 123 |
| GAPDH | GGTCTCCTCTGACTTGAACA | GTGAGGGTCTCTCTCTTCCT | 221 |
Publisher’s Note: MDPI stays neutral with regard to jurisdictional claims in published maps and institutional affiliations. |
© 2022 by the authors. Licensee MDPI, Basel, Switzerland. This article is an open access article distributed under the terms and conditions of the Creative Commons Attribution (CC BY) license (https://creativecommons.org/licenses/by/4.0/).
Share and Cite
Chang, Y.-H.; Chu, T.-Y.; Ding, D.-C. Spontaneous Transformation of a p53 and Rb-Defective Human Fallopian Tube Epithelial Cell Line after Long Passage with Features of High-Grade Serous Carcinoma. Int. J. Mol. Sci. 2022, 23, 13843. https://doi.org/10.3390/ijms232213843
Chang Y-H, Chu T-Y, Ding D-C. Spontaneous Transformation of a p53 and Rb-Defective Human Fallopian Tube Epithelial Cell Line after Long Passage with Features of High-Grade Serous Carcinoma. International Journal of Molecular Sciences. 2022; 23(22):13843. https://doi.org/10.3390/ijms232213843
Chicago/Turabian StyleChang, Yu-Hsun, Tang-Yuan Chu, and Dah-Ching Ding. 2022. "Spontaneous Transformation of a p53 and Rb-Defective Human Fallopian Tube Epithelial Cell Line after Long Passage with Features of High-Grade Serous Carcinoma" International Journal of Molecular Sciences 23, no. 22: 13843. https://doi.org/10.3390/ijms232213843
APA StyleChang, Y.-H., Chu, T.-Y., & Ding, D.-C. (2022). Spontaneous Transformation of a p53 and Rb-Defective Human Fallopian Tube Epithelial Cell Line after Long Passage with Features of High-Grade Serous Carcinoma. International Journal of Molecular Sciences, 23(22), 13843. https://doi.org/10.3390/ijms232213843

